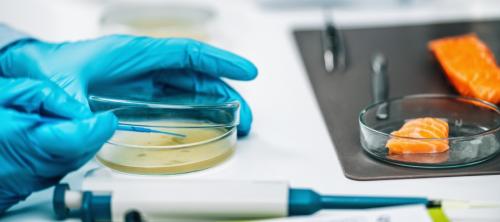
seguridad alimentaria

La UE ha dado un paso más hacia el establecimiento de objetivos vinculantes para reducir considerablemente el desperdicio alimentario de aquí a 2030. El Consejo de la Unión Europea ha adoptado su posición sobre la revisión selectiva de la Directiva Marco sobre Residuos, que se centra especialmente en el despedicio alimentario y los residuos textiles.